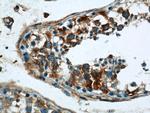
RTN4/NOGO Antibody in Immunohistochemistry (Paraffin) (IHC (P))
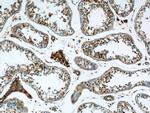
RTN4/NOGO Antibody in Immunohistochemistry (Paraffin) (IHC (P))

Search
Proteintech
RTN4/NOGO Polyclonal Antibody
{{$productOrderCtrl.translations['antibody.pdp.commerceCard.promotion.promotions']}}
{{$productOrderCtrl.translations['antibody.pdp.commerceCard.promotion.viewpromo']}}
{{$productOrderCtrl.translations['antibody.pdp.commerceCard.promotion.promocode']}}: {{promo.promoCode}} {{promo.promoTitle}} {{promo.promoDescription}}. {{$productOrderCtrl.translations['antibody.pdp.commerceCard.promotion.learnmore']}}

Please note: We are reviewing Western blot images included in the antibody testing data in our catalog, including those provided by third parties. Unless expressly labeled or annotated as “raw-unedited”, Western blot images included in the antibody testing data in our catalog may have been edited, optimized or otherwise adjusted for presentation.
产品信息
10950-1-AP
种属反应
已发表种属
宿主/亚型
分类
类型
抗原
偶联物
形式
浓度
规格
纯化类型
保存液
内含物
保存条件
运输条件
产品详细信息
Immunogen sequence: MEDLDQSPL VSSSDSPPRP QPAFKYQFVR EPEDEEEEEE EEEEDEDEDL EELEVLERKP AAGLSAAPVP TAPAAGAPLM DFGNDFVPPA PRGPLPAAPP VAPERQPSWD PSPVSSTVPA PSPLSAAAVS PSKLPEDDEP PARPPPPPPA SVSPQAEPVW TPPAPAPAAP PSTPAAPKRR GSSGSVVVDL LYWRDIKKTG VVFGASLFLL LSLTVFSIVS VTAYIALALL SVTISFRIYK GVIQAIQKSD EGHPFRAYLE SEVAISEELV QKYSNSALGH VNCTIKELRR LFLVDDLVDS LKFAVLMWVF TYVGALFNGL TLLILALISL FSVPVIYERH QAQIDHYLGL ANKNVKDAMA KIQAKIPGLK RKAE (1-373 aa encoded by BC012619)
靶标信息
Nogo, also known as RTN4, encodes a membrane protein that limits axon growth and regeneration in the central nervous system. The gene produces multiple isoforms (Nogo-A, Nogo-B, Nogo-C) via alternative promoters and splicing; Nogo-A is highly expressed in oligodendrocytes and is the principal inhibitor of neurite outgrowth. Nogo engages receptors including NgR1 (RTN4R), LINGO1, and p75 or TROY, activating RhoA/ROCK signaling that stabilizes growth cone collapse and restricts plasticity after injury. Beyond axon guidance, Nogo isoforms contribute to membrane dynamics, endoplasmic reticulum structure, vascular function, and immune signaling. Experimental blockade of Nogo or its receptor complex can enhance sprouting and functional recovery in animal models, making the pathway a target for therapies in spinal cord injury and stroke.
仅用于科研。不用于诊断过程。未经明确授权不得转售。
生物信息学
蛋白别名: Foocen; Neurite outgrowth inhibitor; Neuroendocrine-specific protein; Neuroendocrine-specific protein C homolog; Nogo protein; NSP; Reticulon 4; Reticulon-4; Reticulon-5; RTN-x; Rtn4
基因别名: 1110020G17Rik; AA407876; AA409940; AA960376; ASY; C130026I10Rik; KIAA0886; mKIAA0886; mKIAA4153; My043; NgA; NOGO; Nogo-A; Nogo-B; Nogo-C; NSP-CL; RTN4; SP1507
UniProt ID: (Mouse) Q99P72
Entrez Gene ID: (Mouse) 68585



